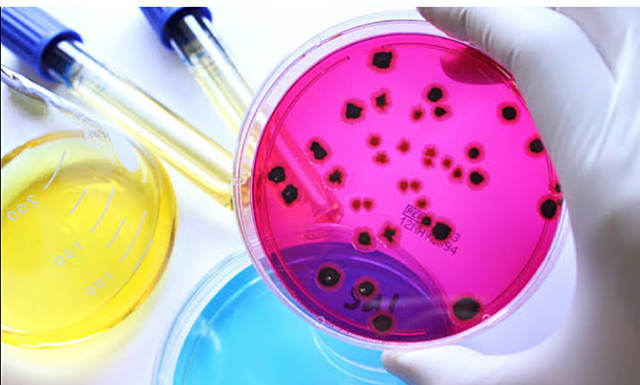
Microbiología- Luis pasteur

-
El principio de Arquímedes es el principio físico que afirma: «Un cuerpo total o parcialmente sumergido en un fluido en reposo experimenta un empuje vertical hacia arriba igual al peso del fluido desalojado».
-
es una teoría astronómica que sitúa a la Tierra en el centro del universo, y a los astros, incluido el Sol, girando alrededor de la Tierra (geo: Tierra; centrismo: agrupado o de centro).
-
es un modelo astronómico según el cual la Tierra y los planetas se mueven alrededor del Sol relativamente estacionario y que está en el centro del universo
-
Las leyes de Kepler fueron enunciadas por Johannes Kepler para describir matemáticamente el movimiento de los planetas en sus órbitas alrededor del Sol.
-
El telescopio que construyó Galileo en 1609 era un telescopio de refracción, con lente convexa delante y una lente ocular cóncava.
-
la principal obra escrita por René Descartes y una obra fundamental de la filosofía occidental con implicaciones para el desarrollo de la filosofía y de la ciencia.
-
En las matemáticas, el triángulo de Pascal es una representación de los coeficientes binomiales ordenados en forma de triángulo.
-
La microbiología es la ciencia encargada del estudio y análisis de los microorganismos,[1] seres vivos diminutos no visibles al ojo humano
-
La dinamita es un explosivo muy potente compuesto por nitroglicerina, una sustancia explosiva líquida a temperatura ambiente y muy inestable que al ser absorbida en un medio sólido
-
Un pararrayos es un instrumento cuyo objetivo es atraer un rayo ionizado del aire para conducir la descarga hacia la tierra, de tal modo que no cause daños a personas o construcciones.